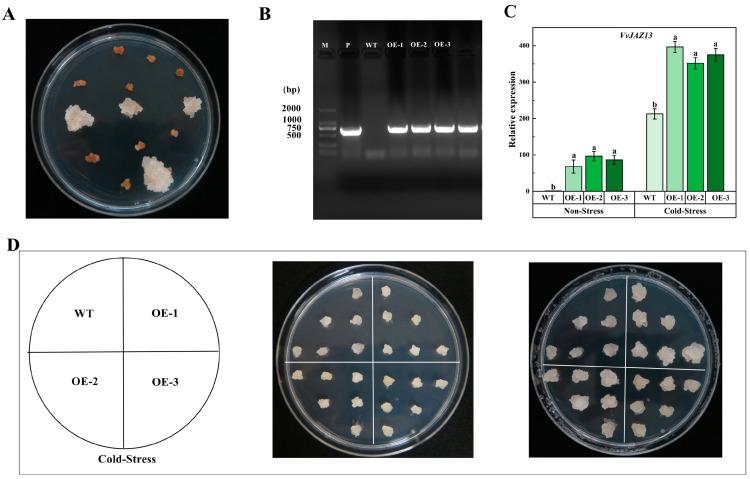

正向调控拟南芥和葡萄的耐寒性。
Positively Regulates Cold Tolerance in and Grape.
作者信息
Che Lili, Lu Shixiong, Gou Huimin, Li Min, Guo Lili, Yang Juanbo, Mao Juan
机构信息
College of Horticulture, Gansu Agricultural University, Lanzhou 730070, China.
出版信息
Int J Mol Sci. 2024 Apr 18;25(8):4458. doi: 10.3390/ijms25084458.
Cold stress adversely impacts grape growth, development, and yield. Therefore, improving the cold tolerance of grape is an urgent task of grape breeding. The Jasmonic acid (JA) pathway responsive gene plays a key role in plant response to cold stress. However, the role of in response to low temperatures in grape is unclear. In this study, was cloned from the 'Pinot Noir' ( cv. 'Pinot Noir') grape, and the potential interacting protein of VvJAZ13 was screened by yeast two-hybrid (Y2H). The function of under low temperature stress was verified by genetic transformation. Subcellular localization showed that the gene was mainly expressed in cytoplasm and the nucleus. Y2H indicated that VvF-box, VvTIFY5A, VvTIFY9, Vvbch1, and VvAGD13 may be potential interacting proteins of VvJAZ13. The results of transient transformation of grape leaves showed that improved photosynthetic capacity and reduced cell damage by increasing maximum photosynthetic efficiency of photosystem II (Fv/Fm), reducing relative electrolyte leakage (REL) and malondialdehyde (MDA), and increasing proline content in overexpressed lines (OEs), which played an active role in cold resistance. Through the overexpression of in and grape calli, the results showed that compared with wild type (WT), transgenic lines had higher antioxidant enzyme activity and proline content, lower REL, MDA, and hydrogen peroxide (HO) content, and an improved ability of scavenging reactive oxygen species. In addition, the expression levels of and genes related to cold response were up-regulated in transgenic lines. To sum up, is actively involved in the cold tolerance of and grape, and has the potential to be a candidate gene for improving plant cold tolerance.
低温胁迫对葡萄的生长、发育和产量产生不利影响。因此,提高葡萄的抗寒性是葡萄育种的一项紧迫任务。茉莉酸(JA)途径响应基因在植物对低温胁迫的响应中起关键作用。然而,其在葡萄低温响应中的作用尚不清楚。本研究从‘黑比诺’(品种‘Pinot Noir’)葡萄中克隆了该基因,并通过酵母双杂交(Y2H)筛选了VvJAZ13的潜在互作蛋白。通过遗传转化验证了该基因在低温胁迫下的功能。亚细胞定位表明该基因主要在细胞质和细胞核中表达。Y2H表明VvF-box、VvTIFY5A、VvTIFY9、Vvbch1和VvAGD13可能是VvJAZ13的潜在互作蛋白。葡萄叶片瞬时转化结果表明,该基因通过提高过表达株系(OEs)的光系统II最大光合效率(Fv/Fm)、降低相对电导率(REL)和丙二醛(MDA)含量以及增加脯氨酸含量,提高了光合能力并减少了细胞损伤,在抗寒方面发挥了积极作用。通过在拟南芥和葡萄愈伤组织中过表达该基因,结果表明与野生型(WT)相比,转基因株系具有更高的抗氧化酶活性和脯氨酸含量,更低的REL、MDA和过氧化氢(H₂O₂)含量,以及更强的清除活性氧的能力。此外,转基因株系中与低温响应相关的基因的表达水平上调。综上所述,该基因积极参与拟南芥和葡萄的抗寒性,有潜力成为提高植物抗寒性的候选基因。